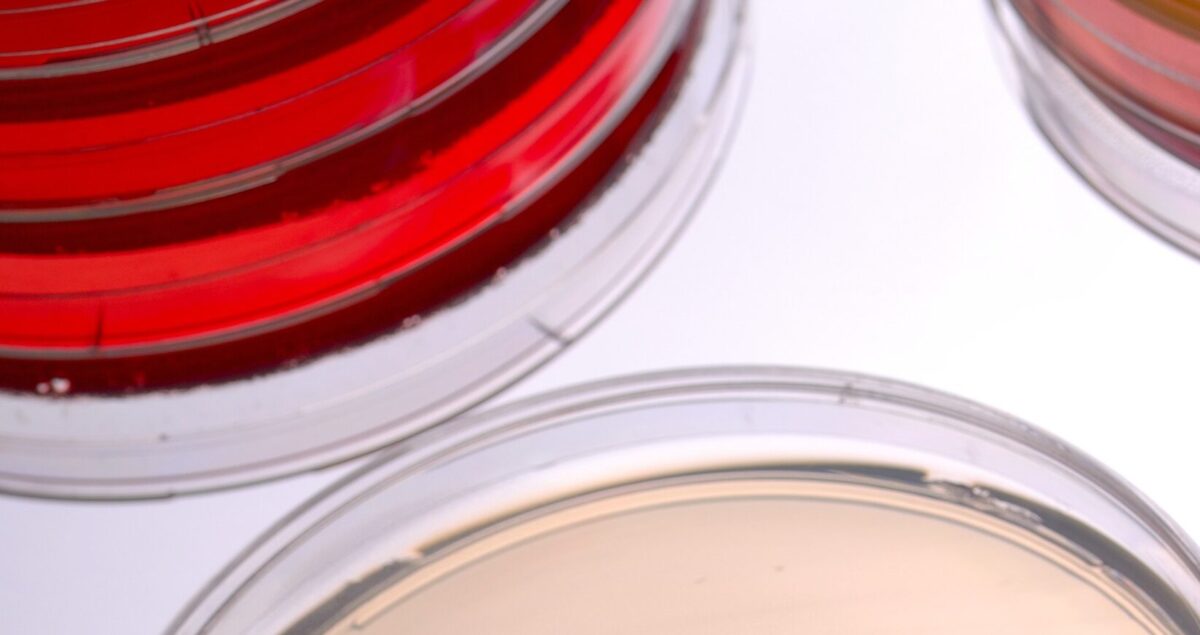

Aujourd’hui, la plupart des bio-collecteurs offrent une vitesse de prélèvement de 100l/min. Si cela parait être la « norme », ce n’est pas le cas. Il s’agit plutôt d’un point sur lequel jusqu’à maintenant, aucun fabricant ne s’était penché : réduire la durée du temps de prélèvement sans en altérer la qualité.
En effet, la norme ISO 14698-1, Salles propres et environnements maitrisés apparentés – Maitrise de la biocontamination, vous invite à choisir une méthode de prélèvement par impaction suffisamment rapide pour impacter les micro-organismes sur la gélose sans impacter la qualité du prélèvement. Récemment remplacée par la norme NF EN 17141, qui évoque une vitesse de prélèvement « typiquement de 100l/min », sans restriction particulière.
Mais alors, que se passe-t-il si on passe sur un bio-collecteur 200L/min ?

Le centre hospitalier de St Lô a réalisé pour vous une étude comparative entre leur préleveur actuel, avec une tête et une vitesse d’impaction à 100l/min, et le TRIO.BAS DUO deux têtes avec une vitesse de 200L/min. Au total, 16 points de prélèvements ont été testés en parallèle, avec un lot unique de gélose TSA. Et voici le résultat !
Idée reçue n°1 : le 200l/min augmente le risque de dessèchement des géloses
FAUX ! Dans cette étude, 3 mesures du poids des boites ont été réalisées : avant prélèvement, après prélèvement et après incubation.

Et les résultats montrent que plus le volume prélevé est grand, plus le phénomène d’évaporation s’accentue, ce qui se répercute après incubation, mais que la vitesse d’impaction n’influe pas sur ce paramètre. Par ailleurs, le secteur pharmaceutique défini dans ses bonnes pratiques une tolérance de perte d’eau de 20% maximum garantissant l’absence d’impact sur les performances du milieu.de perte. Avec 11.2%, le TRIO.BAS 200l/min est totalement conforme.
Idée reçue n°2 : la gélose va se rétracter et se fissurer
FAUX ! Les conséquences d’une évaporation après incubation peuvent être désastreuses pour la gélose : elle se rétracte, se fissure, rendant la lecture compliquée et les résultats peu fiables ! À la suite de l’incubation, le contrôle visuel des géloses a révélé l’absence de fissures et de rétractation sur … la totalité des boites !

Idée reçue n°3 : je vais gagner du temps
VRAI ! On a d’un côté un appareil avec une tête qui prélève à 100l/min. Donc pour un volume de 1000L, 10 minutes vont être nécessaires avant de relancer un second prélèvement sur une autre gélose, ou d’aller sur un autre point de prélèvement.
De l’autre, on a un TRIO.BAS DUO avec deux têtes qui prélèvent à 200L/min. Ici, 5 minutes seulement vont être nécessaires pour réaliser deux prélèvements en simultané de 1000L chacun sur deux géloses. Si vos analyses portent sur la flore totale et les levure moisissures en parallèle, ce n’est plus 20 minutes de prélèvement, mais seulement 5 ! Le temps n’est plus divisé par 2 mais par 4 !
Pour conclure, réaliser un prélèvement d’air avec une vitesse de 200L/min permet réduire le temps de manipulation tout en maintenant le même niveau de qualité de l’analyse.
Résultats définitifs de l’étude :


Vous souhaitez en savoir plus sur notre gamme pour
les prélèvements d’air et des surfaces :
👉 Vous souhaitez en savoir plus sur nos préleveurs d’air et de gaz ? Contactez-nous dès maintenant :
Contact :
« * » indique les champs nécessaires